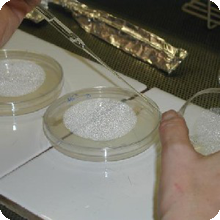

LABORATORIO DI MICOLOGIA E PATOLOGIA FORESTALE
![]() |
Il laboratorio opera come supporto tecnico-scientifico per le attività di ricerca applicata in campo biologico ed agronomico. La strumentazione di cui è dotata la struttura e la presenza di personale specializzato permettono lo svolgimento di indagini, sia di ricerca applicata sia di tipo analitico, su differenti tematiche. A supporto delle proprie attività il laboratorio dispone di una serra riscaldata e di un tunnel in policarbonato con irrigazione computerizzata. |
Attività
- monitoraggio della micorrizia in tartufaie di impianto e naturali;
- assistenza tecnica ai vivai forestali regionali per l’ottimizazione delle produzioni vivaistico forestali (micorrizazione con tartufo e biofertilizzazione con funghi micorrizici) e certificazione della micorrizazione;
- diagnostica delle micopatologie e di quelle più recenti di tipo abiotico (danni da ozono o simili).